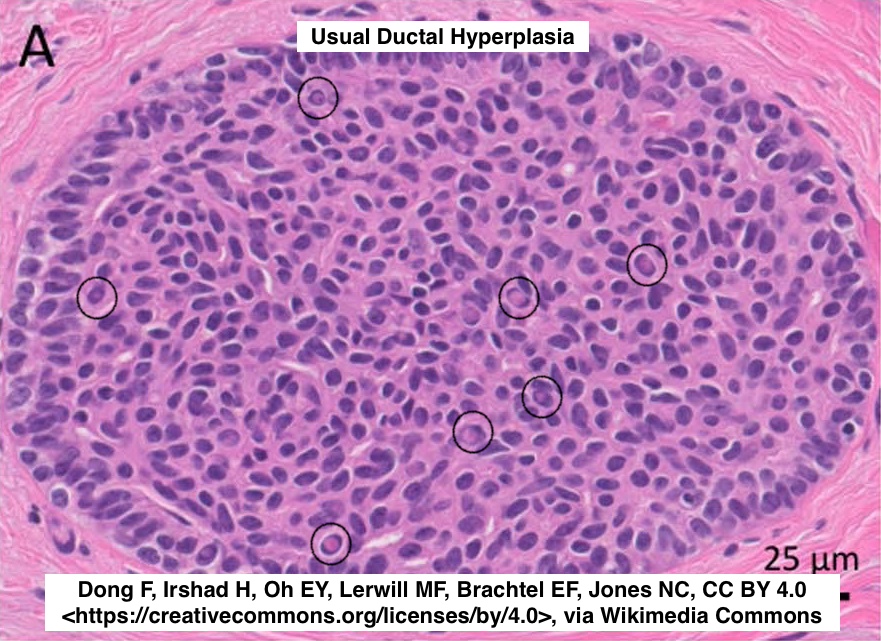
Path4People's tweet image. 🔬 Usual Ductal Hyperplasia (Breast)

🔬In addition to the windswept architecture and slit like spaces, another clue for Usual Ductal Hyperplasia ⬇️ 
👀👀Intranuclear Cytoplasmic Pseudoinclusion👀 👀 

 #pathx #path4people #breastpath #pathagonia #breastx #medx #pathx #pathology

Maj (Dr) Saurabh Moond
@saurabhmoond
MD-Pathology, Veteran , Doctor, Army Hospital (Research & Referral) India , Retweets not endorsement
You might like
WALTHARD CELL NESTS seen in the Serosa of fallopian tube. Resemble transitional epithelium showing central cystic change.


25/F 2x2 cm Breast lump #cytopath #pathtwitter #breast @pepeheffernan @vi_monappa @kriyer68 @DrGeeONE @kr_abhisek




Procalcitonin Because interferon gamma is triggered by viruses and suppresses procalcitonin, so procalcitonin can differentiate bacterial vs viral etiology, so procalcitonin testing can be used to reduce lower respiratory tract infection abx use without affecting mortality

On the occasion of the Army Medical Corps Raising Day, #Surg Vice Adm Arti Sarin, #DGAFMS salutes the exemplary courage, utmost devotion to duty and the supreme sacrifice made by Sepoy Dhan Singh of #AMC. The soldier was on duty in the cook house of a General Hospital in Northern…

I (finally) completed my CNS tumor notes for "Kurt's Notes" (kurtsnotes.net)! 🧠🧠🧠🧠🧠🧠🧠🧠🧠🧠 Full notes here: schaberg.faculty.ucdavis.edu/wp-content/upl… 🧠🧠🧠🧠🧠🧠🧠🧠🧠🧠




Rs 70,000 For Medical Degree: 14 Fake Doctors Arrested In Gujarat ndtv.com/india-news/rs-…
For the PGY1s in Pathology.. #gynpath #histology #PGY1 #OVARY #normalhistology Image1- mature graffian follicle Image2- Yellow: Granulosa layer Blue: Theca interna Black: Theca externa


"A picture is worth a thousand words!" In publications, specially in Pathology, visuals like illustrations, microscopic images, gross images, special stains, IHC, molecular pathology, graphs, and even cartoons convey more than words ever could. We've seen some great images in…



I just updated my notes on "Soft tissue tumors" for my teaching website, "Kurt's Notes" (kurtsnotes.net). 🔬🔬🔬🔬🔬🔬🔬🔬🔬🔬🔬🔬🔬🔬🔬🔬🔬🔬🔬🔬🔬🔬🔬🔬🔬🔬🔬🔬🔬🔬 Full notes available here: schaberg.faculty.ucdavis.edu/wp-content/upl…




'Cell for scale' 38/M, Pleural fluid @pepeheffernan @saurabhmoond @AnupamaArya12 @CancerCytopath

अब सिर्फ़ @RaoNarbir जी का ही साथ है । #kherkiDaulaToll removal. @AmitShah @nitin_gadkari @PMOIndia @narendramodi @its_AkankshaG @DC_Gurugram @SSikenderpur @MlaSatya @aajtak

Mucinous lesions of the endometrium -60 yo female with hydrometra -Endometrial biopsy with glands with mucin cells, goblet cells and red granules (last 2 pics) IHC: ER neg. PAX-8, CK7, CDX-2 patchy positive. CK20 focal +. p53 wild type. Chromogranin focally + How would you sign…




Mucinous lesions of the endometrium Papillary endometrial proliferations with mucinous metaplasia -Mucinous glands with intraglandular simple papillary structures How would you sign out this endometrial biopsy? See next post 👇 Dr. Wong #isgyp #PathTwitter #PathX #pathresidents…


‘Don’t follow the crowd, let the crowd follow you !’ Thoughts 💭 #PathX #pathtwitter #surgicalpath #BSTpath #pathology #histopath #softtissue #oncopath

🔬 Usual Ductal Hyperplasia (Breast) 🔬In addition to the windswept architecture and slit like spaces, another clue for Usual Ductal Hyperplasia ⬇️ 👀👀Intranuclear Cytoplasmic Pseudoinclusion👀 👀 #pathx #path4people #breastpath #pathagonia #breastx #medx #pathx #pathology
Claudin 18.2 immunohistochemistry is new for gastric and esophageal adenocarcinomas. Benign gastric mucosa is the internal positive control. 2+-3+ membrane staining in ≥75% of tumor cells is the cutoff for use of anti-CLDN18.2 (zolbetuximab). #UMiamiPath PMID: 39098518.


#SundayEveningMotivation ⬇️ shows how doing nothing vs incremental change everyday could help immensely in all spheres of LIFE! 😇 Try for yourself! Being conservative & consistent is the 🔑 Good evening! #HealthFIPassion

52 weeks 💰 savings challenge ‼️ Have you ever tried this savings challenge to save: *💯₹ in week 1 * 200₹ in week 2 * 300₹ in week 3 … … * 5100₹ in week 51 * 5200₹ in week 52 Voila!!! 137800 ₹ saved in a year! Who all are ready? Use the arithmetic…
60+ female with axillary lymph node. Ultrasound-guided core biopsies. I made a diagnosis. Case reviewed elsewhere and called something else. Maybe no "right" answer and so a good case for discussion? Basic IHC in next tweet, then poll in one after. #pathology





United States Trends
- 1. #BaddiesUSA 52.3K posts
- 2. Rams 28.2K posts
- 3. Scotty 9,077 posts
- 4. #TROLLBOY 1,729 posts
- 5. Cowboys 97.8K posts
- 6. Chip Kelly 7,992 posts
- 7. Eagles 138K posts
- 8. Stafford 14K posts
- 9. Bucs 12.1K posts
- 10. Baker 20.6K posts
- 11. Raiders 65.8K posts
- 12. #RHOP 10.8K posts
- 13. Stacey 29.7K posts
- 14. #ITWelcomeToDerry 13.5K posts
- 15. Todd Bowles 1,952 posts
- 16. Teddy Bridgewater 1,165 posts
- 17. Ahna 6,199 posts
- 18. Lemmy 4,521 posts
- 19. DOGE 159K posts
- 20. Vin Diesel 1,010 posts
You might like
Something went wrong.
Something went wrong.









![drsys02's profile picture. Associate Professor [Pathology] @ India # loves Art; Painting Photography.](https://pbs.twimg.com/profile_images/1955512665096269824/8zz_CxnO_x96.jpg)


































































































































![drsys02's profile picture. Associate Professor [Pathology] @ India # loves Art; Painting Photography.](https://pbs.twimg.com/profile_images/1955512665096269824/8zz_CxnO.jpg)
